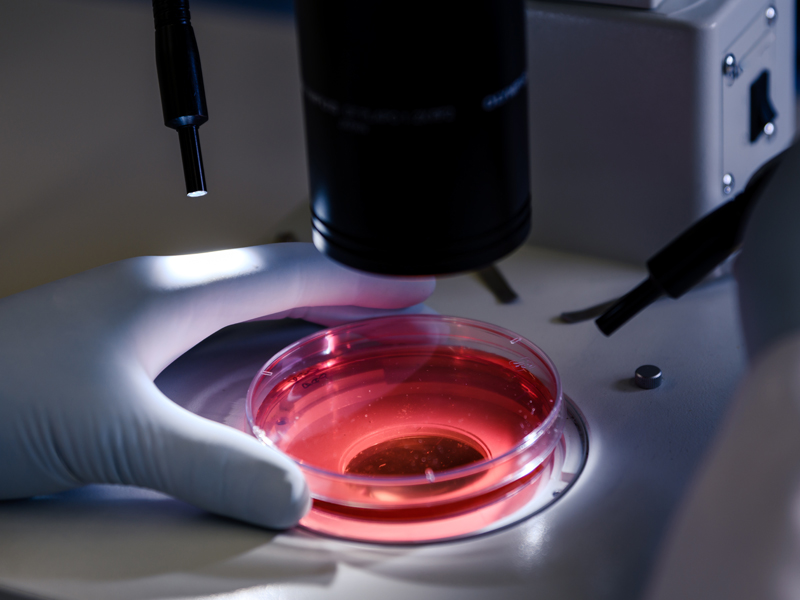
White Couple in Shock After Giving Birth to Black Baby in Embryo Mixup That Exposed How IVF Industry Lacks Accountability

Peiffer Wolf is representing victims of a recent embryo disaster, allegedly caused by a corrupted batch of embryo culture media manufactured by CooperSurgical. In December 2023, Cooper issued an urgent recall for specific lots of its embryo solution (LifeGlobal global® Media). Many victims have already received a copy of the recall from their fertility doctors or fertility clinics. However, it is possible that hundreds or thousands of additional victims exist and haven’t been notified that their eggs and/or embryos were impacted by Cooper Surgical’s recalled solution.
If you have learned that your eggs and/or embryos were in contact with Cooper Surgical’s toxic embryo culture media, please contact Peiffer Wolf by filling out a Contact Form or by calling us at 415-766-3544 for a FREE Consultation.

CooperSurgical IVF Media Recall | Embryo Destruction Lawsuits
In December 2023, CooperSurgical sent a recall notice to Fertility Clinics, IVF Clinics, and Fertility Doctors after many reports of failures in the development of embryos in contact with the company’s embryo culture media.
In the case of two couples represented by Peiffer Wolf, their embryos suddenly stopped growing or proved non-viable just shortly after their fertility clinics created their embryos. Their fertility doctors were surprised by the highly unusual result. After investigating, the fertility doctors learned that CooperSurgical’s embryo culture media likely caused the destruction of the embryos.
The doctors confirmed the embryos had been viable prior to coming into contact with the culture media, and then were killed. Couples may no longer be able to have biologically related children as a result.
Multiple lawsuits have been filed by Peiffer Wolf on behalf of couples whose embryos were destroyed. Peiffer Wolf has filed lawsuits in the Superior Court of California, as well as in the United States District Court for the Northern District of California on behalf of couples whose embryos were destroyed.
Peiffer Wolf Parter Adam Wolf is also representing more than 100 additional victims of CooperSurgical’s Toxic Embryo Culture Media:
“Many affected patients have not been properly informed, and CooperSurgical has not publicly disclosed how many embryos have been killed due to this disaster. The families deserve answers. This is not a problem that CooperSurgical can sweep under the rug. Human embryos are precious and irreplaceable, and the families are utterly devastated.”
CooperSurgical IVF Media Recall | Have I been impacted?
Embryo culture media plays a pivotal role in the IVF process. During IVF, eggs are extracted from a woman’s ovaries and fertilized with sperm to create viable embryos. The process of extracting human eggs from a woman is grueling, typically requiring significant medication, ultrasound monitoring, other scans to check the development of the eggs, and a surgery procedure to collect the eggs. Sperm is mixed with the eggs in a laboratory to create embryos, and the culture media is used to allow the embryos to grow.
Unfortunately, CooperSurgical only sent the recall notice to the Fertility Clinics, and not all clinics are notifying their patients. Patients who had their fertility treatments between October and December of 2023 are likely to have been impacted by CopperSurgical’s toxic embryo culture media. You can reach out to your Fertility Clinic and ask whether they used the following recalled lots:
231020-018741
231020-018742
231020-018743
My embryos were destroyed by CooperSurgical’s IVF Media. What should I do?
After being contacted nearly a decade ago by a client whose embryos were lost or destroyed, the attorneys of Peiffer Wolf have fought hard to hold fertility clinics accountable for their negligence. Since then, we’ve been able to represent hundreds of the strongest and most amazing families in a number of fertility issues: lost embryos, destroyed embryos, inadequate medical testing, fertility doctor misconduct, fertility fraud, embryo implantation into the wrong woman, wrong sperm used to fertilize embryos, and countless others.
Standing beside our clients, we’ve been able to provide a platform for other families to step forward and tell their stories. Moreover, we’ve been able to provide a pathway to recovery for their losses.
If you have learned that your eggs and/or embryos were destroyed by CooperSurgical’s toxic embryo culture media, you should contact us immediately. We have represented tens of thousands of clients who have been in your situation; our attorneys know how important it is for families to count on a compassionate team, so we create a safe space for everyone to share their story, where we can communicate with you with the utmost care and transparency.
“It was then that we learned that our precious embryos had been lost or destroyed. It was like the whole bottom fell out of our world and we at first did not know what to do. It was after much prayer and deliberation that we decided it was our mission to make sure that this kind of thing never happened again.” (Peiffer Wolf Client)
Please contact us by filling out a Contact Form or by calling us at 415-766-3544 for a FREE Consultation.
Fertility Industry | Key Information
- The $2.1 billion fertility center industry in the United States is big business.
- More than one out of ten women seek fertility-related services from the roughly 500 U.S. clinics, resulting in 69,000 live births a year – nearly 2 percent of all children born annually.
- In the absence of meaningful state and regulatory oversight of the fertility center world, it would be comforting to think that a system of industry self-regulation would work as a substitute. But the self-regulation that exists today is weak and full of holes.
- The Human Fertilization and Embryology Authority oversees nearly every aspect of 69,000 fertility procedures a year at 131 licensed clinics in the United Kingdom. The key elements of the work of the Authority are as follows: (1) clinics must apply for a license from the Authority to operate; (2) licenses are granted for up to four years at a time; (3) inspections are carried out periodically and can be done on a surprise basis; (4) inspections can result in recommended changes to clinic practices and even outright license revocation; (5) the Authority sets standards for clinics to ensure high-quality care; (6) it provides guidance to clinics and research centers on how to meet all legal requirements. The HFEA’s actions are highly transparent, including the online publication of the outcomes of all clinic inspections. It also provides the public with information about IVF and other procedures.
FREE CONSULTATION | 415-766-3544
Peiffer Wolf is nationally recognized for representing victims of fertility clinic misconduct and fertility doctor misconduct, including the destruction or loss of eggs and embryos.
If you have learned that your eggs and/or embryos were in contact with CooperSurgical’s toxic embryo culture media, please contact Peiffer Wolf by filling out a Contact Form or by calling us at 415-766-3544 for a FREE Consultation.
FERTILITY MISCONDUCT IN THE NEWS
Yes. Please call us or use our contact form to request a Free Case Evaluation. We have a national team of attorneys and staff who look forward to speaking with you.
Typically, we represent clients on contingency fee agreements. If we take your case under a contingency fee arrangement, you won’t owe our firm any legal fees unless we are able to recover money for you.
Our contingency fee agreements are usually based on a percentage of the amount we recover for our clients. The contingency fee amount is determined by the type of case, our estimate of how long it will take to resolve your case, and our estimate of the litigation costs we will advance in your case. Each engagement agreement includes the details of the fee arrangement. Questions about our fee agreements are welcomed and encouraged.
In most litigation matters, it is extremely difficult – practically impossible – to predict how long it will take to resolve a particular case. Every case is different, and we will do our best to provide you with an estimate based on your case and our experience with similar cases. Moreover, we will do our best to keep you updated and manage expectations along the way.